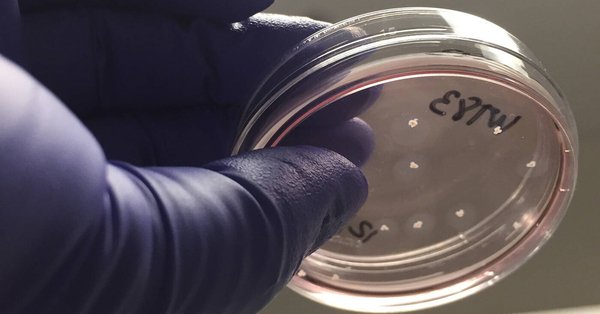
Tweet card summary image

David Úbeda
@ub3d4
Followers
968
Following
2K
Media
254
Statuses
4K
Universidad Miguel Hernández de Elche, Doctor en Inteligencia Artificial y Ciencia de Datos.
Elche
Joined November 2011
Un estudio determina que el humo del incienso es más tóxico que el del tabaco
elconfidencial.com
Aún está por determinar si los resultados con altos agentes tóxicos estarían presentes en todas las variantes de este producto
0
0
2
Y si empezamos a dejar hueco al deporte femenino? 1. 12 partidos, 12 victorias. 72 goles a favor, 0 en contra 2. Primera española en tener un balón de oro 3. Oro en los juegos olímpicos de Tokio 4. Campeonas del mundo en vela 470 Y muchas más que han logrado logros en 2021
Las 12 campanadas de 2021: 1. Despedida de Messi 2. Liga del Atleti 3. Jon Rahm 4. Anillo de los Bucks 5. Liga del Barça basket 6. Champions del Chelsea 7. Europa League del Villarreal 8. Despedida de Sergio Ramos 9. Adiós del Kun 10. Djokovic 11. Nadal 12. Verstappen
7
110
457
🚨Atención: hemos tenido constancia de un ataque de #PHISING a la @UniversidadMH Si recibes un correo pidiéndote tus credenciales de correo NO CONTESTES. Estamos trabajando para solucionarlo.
0
19
19
"Neuronas humanas 'in vitro' aprenden a jugar a videojuegos más rápido que la IA"
elconfidencial.com
Científicos australianos han enseñado a neuronas humanas en el laboratorio a jugar al clásico videojuego ‘Pong’. Lo han conseguido en solo 5 minutos, mucho más rápido que la inteligencia artificial
0
0
4
Watch a Tesla on the latest version of "Full Self-Driving" Beta almost hit a pedestrian who had a walk sign, try going down railroad tracks, & glitch to the point where the driver COULD NOT TAKE CONTROL. All in 21-min drive. Full video from @Aiaddict1: https://t.co/uAzrze6q26
267
2K
8K
Después decís que no hay pisos baratos.
24
112
528
Cuando eres del Barça y te alegras de que gane el Madrid... https://t.co/aESv8X7ymb
elpais.com
Una sentencia de la Audiencia Nacional condena al fisco a compensar a la operadora por las cantidades pagadas de más por los beneficios de 2009 y 2010
0
0
1
Goliat, hoy he venido a vencerte. Hace 24 años tú me ganaste. Me masticaste y me escupiste, sin moverte. Hoy, sin embargo, soy más fuerte, más valiente, y he venido a vencerte. Dedicado a @CeliaDominguezR hoy armada con una honda, llena de fortaleza y valentía.
2
1
5
Un ciberataque basado en caracteres invisibles o ambiguos permite introducir puertas traseras en código JavaScript
genbeta.com
Imagínate, por un momento, una puerta trasera insertada en un código de programación que se le pase por alto a cualquier revisor humano y que pocos IDEs...
0
1
2
Oficial: Movistar no compartirá su fibra en estas casi 700 ciudades
adslzone.net
La CNMC ha publicado la lista de los 696 municipios competitivos donde Movistar no tendrá que compartir su fibra óptica con otros operadores.
0
1
0
Tesla presenta un seguro que calcula el pago mensual en función de cómo conduces
0
3
10